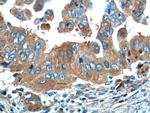
OPTN Antibody in Immunohistochemistry (Paraffin) (IHC (P))

Search
Proteintech
OPTN Monoclonal Antibody (6C1H4)
{{$productOrderCtrl.translations['antibody.pdp.commerceCard.promotion.promotions']}}
{{$productOrderCtrl.translations['antibody.pdp.commerceCard.promotion.viewpromo']}}
{{$productOrderCtrl.translations['antibody.pdp.commerceCard.promotion.promocode']}}: {{promo.promoCode}} {{promo.promoTitle}} {{promo.promoDescription}}. {{$productOrderCtrl.translations['antibody.pdp.commerceCard.promotion.learnmore']}}
产品信息
60293-1-IG
种属反应
宿主/亚型
分类
类型
克隆号
抗原
偶联物
形式
浓度
规格
纯化类型
保存液
内含物
保存条件
运输条件
产品详细信息
Immunogen sequence: VSQLLLCLR EGNQKVERLE VALKEAKERV SDFEKKTSNR SEIETQTEGS TEKENDEEKG PETVGSEVEA LNLQVTSLFK ELQEAHTKLS EAELMKKRLQ EKCQALERKN SAIPSELNEK QELVYTNKKL ELQVESMLSE IKMEQAKTED EKSKLTVLQM THNKLLQEHN NALKTIEELT RKESEKVDRA VLKELSEKLE LAEKALASKQ LQMDEMKQTI AKQEEDLETM TILRAQMEVY CSDFHAERAA REKIHEEKEQ LALQLAVLLK ENDAFEDGGR QSLMEMQSRH GARTSDSDQQ AYLVQRGAED RDWRQQRNIP IHSCPKCGEV LPDIDTLQIH VMDCII (233-577 aa encoded by BC013876)
靶标信息
This gene encodes the coiled-coil containing protein optineurin. Optineurin may play a role in normal-tension glaucoma and adult-onset primary open angle glaucoma. Optineurin interacts with adenovirus E3-14. 7K protein and may utilize tumor necrosis factor-alpha or Fas-ligand pathways to mediate apoptosis, inflammation or vasoconstriction. Optineurin may also function in cellular morphogenesis and membrane trafficking, vesicle trafficking, and transcription activation through its interactions with the RAB8, huntingtin, and transcription factor IIIA proteins. Alternative splicing results in multiple transcript variants encoding the same protein.
仅用于科研。不用于诊断过程。未经明确授权不得转售。
生物信息学
蛋白别名: Ag9 C5; E3-14.7K-interacting protein; FIP 2; FIP-2; FIP-2; HYPL; NRP; TFIIIA-INTP; RAB8-INTP; E3-14.7K-INTP; HIP 7; HIP-7; Huntingtin interacting protein L; Huntingtin yeast partner L; Huntingtin-interacting protein 7; Huntingtin-interacting protein L; interacts with adenovirus E3-14.7KDa, a TNF-alpha cytolysis antagonist; NEMO-related protein; Optic neuropathy-inducing protein; Optineurin; TFIIIA IntP; TFIIIA-IntP; Transcription factor IIIA-interacting protein; transcrption factor IIIA-interacting protein; tumor necrosis factor alpha-inducible cellular protein containing leucine zipper domains; Uban; unnamed protein product
基因别名: ALS12; FIP2; GLC1E; HIP7; HYPL; NRP; OPTN; TFIIIA-INTP
UniProt ID: (Human) Q96CV9
Entrez Gene ID: (Human) 10133